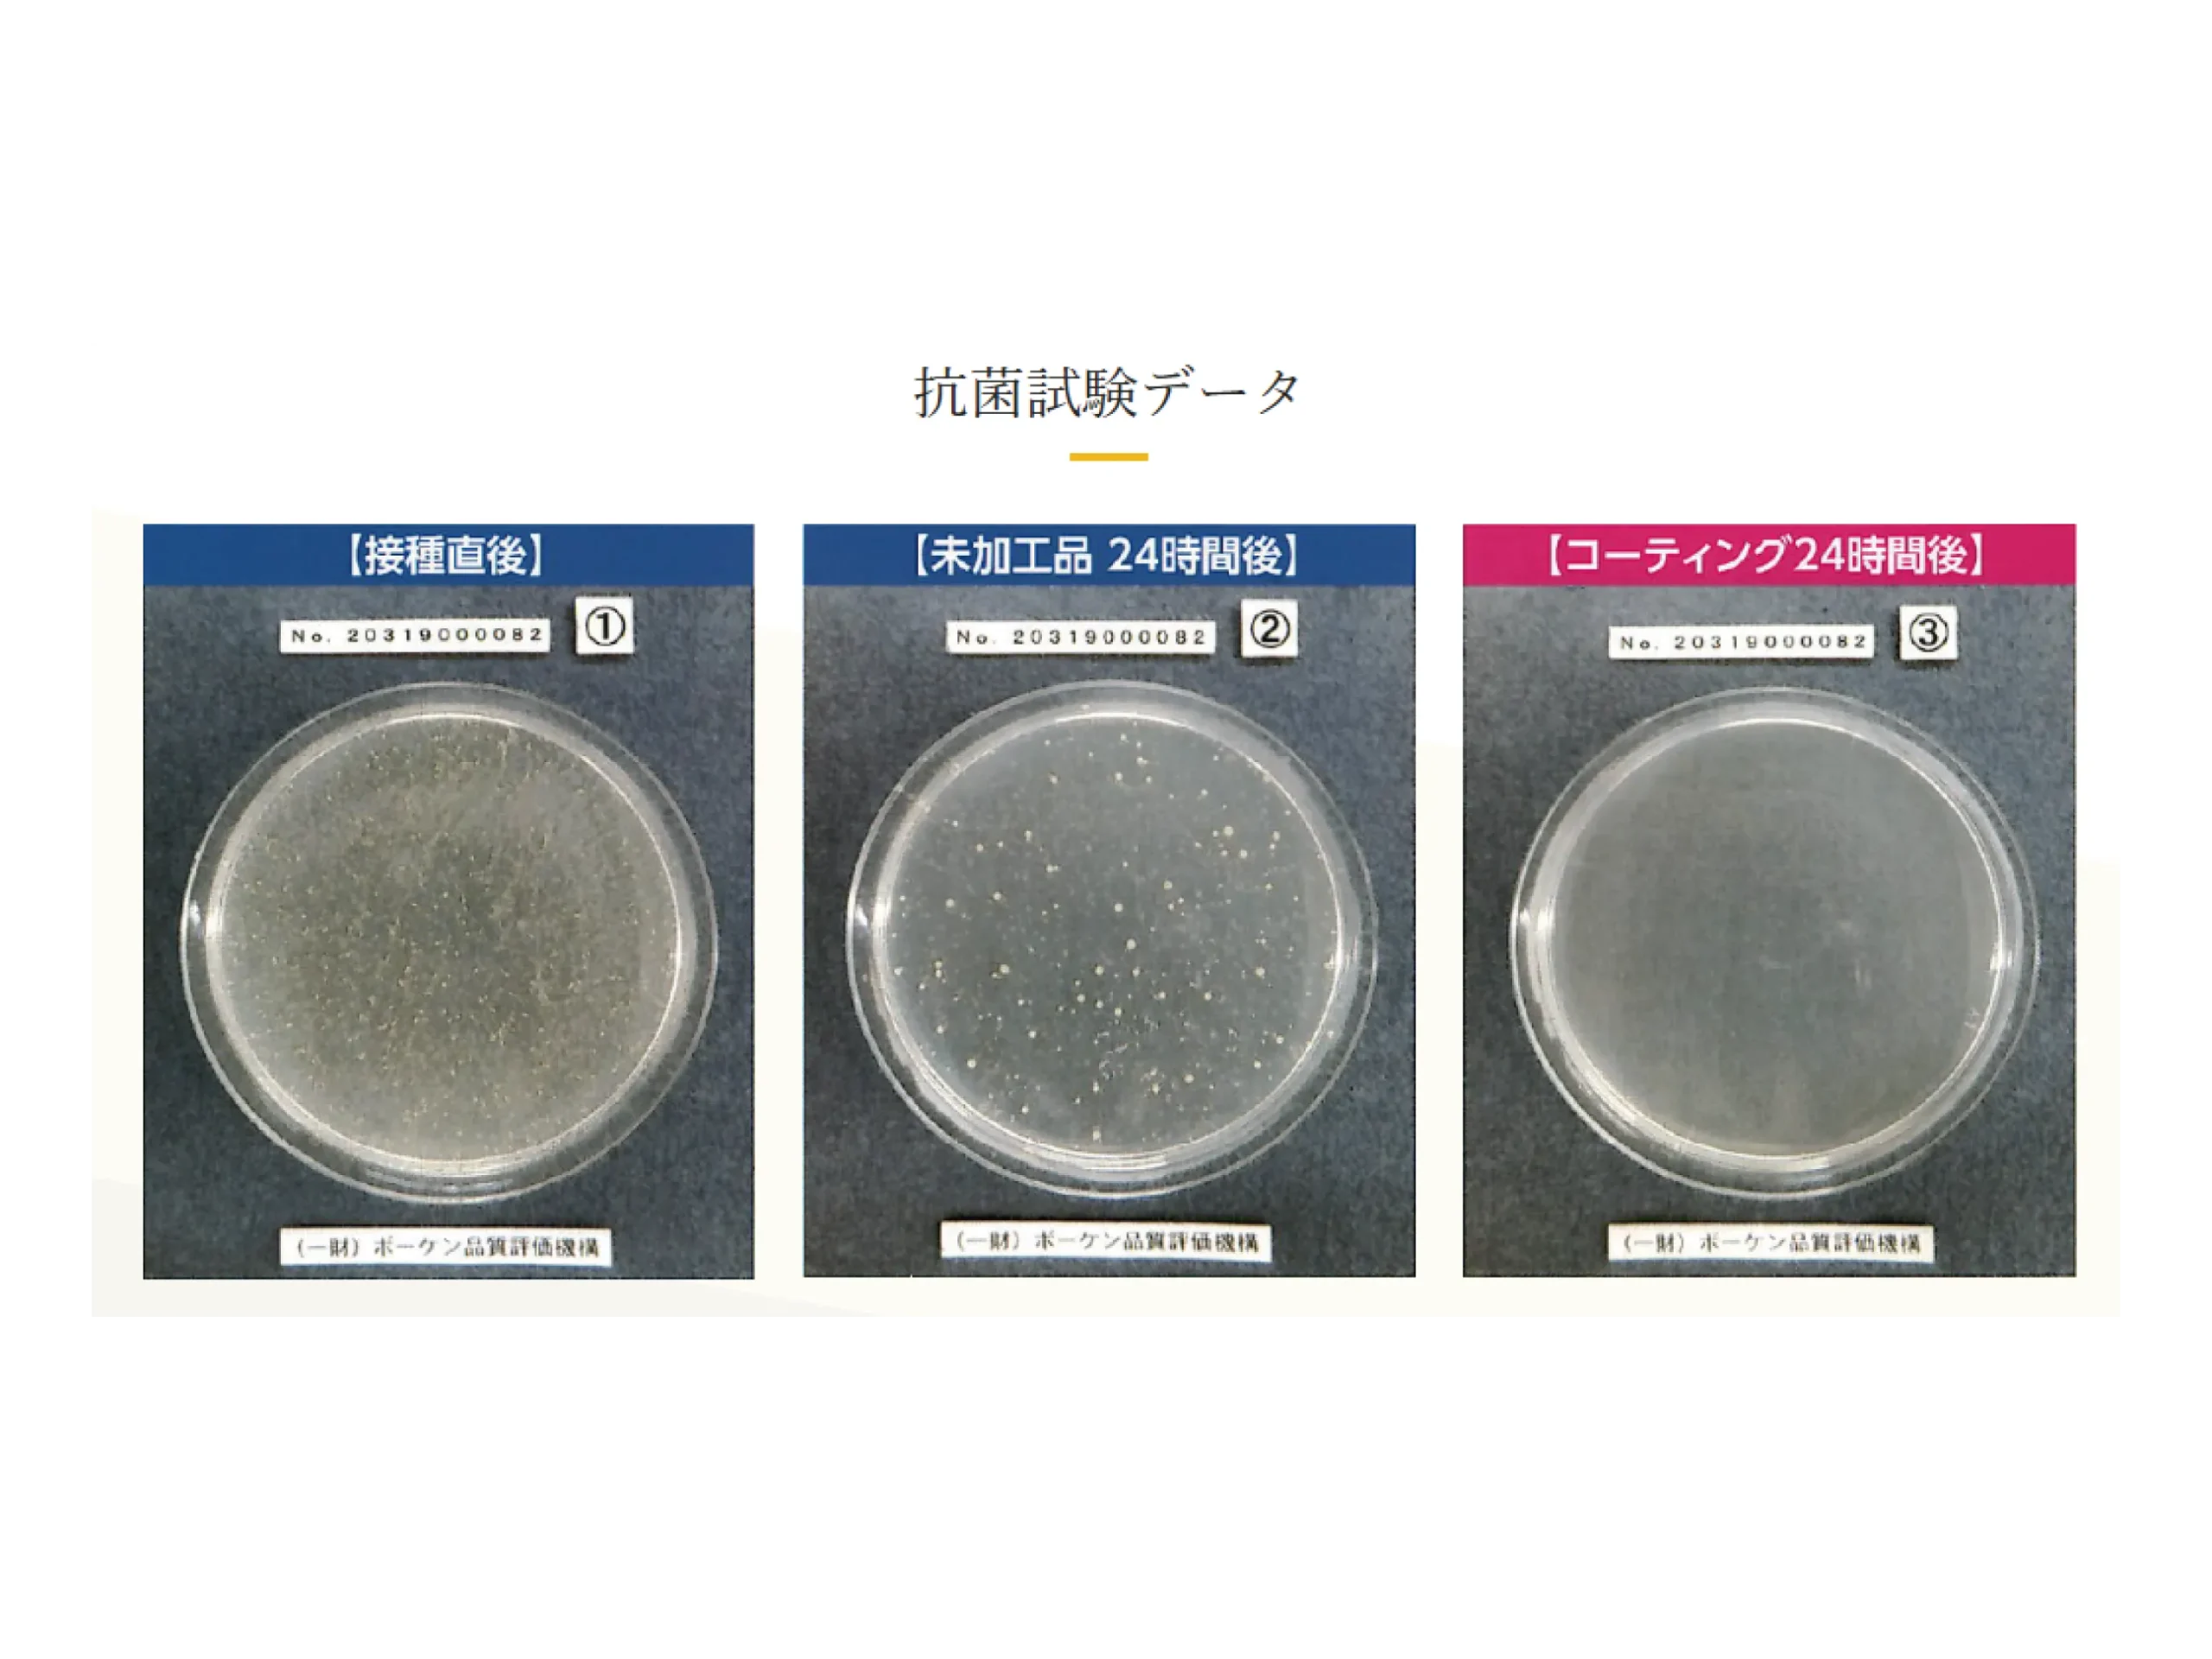

サービス一覧
- 原状回復工事
- リフォーム
- リノベーション
- 内装工事
- 部分改修工事|Room Refine
- ハウスクリーニング
- キッチンフードクリーニング
- キッチンシンク・コンロクリーニング
- 浴室クリーニング
- エアコンクリーニング
- フロアコーティング
- A1フロアコーティングとは
- ブログ・お役立ち情報
施工事例
会社概要
お気軽にお問い合わせください!

サービス一覧
施工事例
会社概要
お気軽にお問い合わせください!

愛知・名古屋でフロアコーティング・床コーティングを検討されている方は、専門業者である当社にぜひご相談ください。
フローリングは年月の経過や日常生活の中で傷や汚れがつきやすく、光沢を失うとお部屋全体が暗く見えてしまいます。
当社では最新のUVフロアコーティングをはじめ、高耐久の床コーティング施工を行い、フローリングの美観と耐久性を長期間キープ。新築住宅の引き渡し時にコーティングを施すことで、子供やペット(犬・猫)がいるご家庭でも安心して暮らせる清潔な環境を維持できます。
さらに、賃貸物件の退去後に必要な原状回復や中古住宅のリフォームでもフロアコーティングは大変効果的です。
擦り傷やくすみを補修しながら美しい光沢を取り戻すことで、入居者に好印象を与え、資産価値を維持・向上させることができます。
愛知・名古屋エリアを中心に数多くの施工実績があり、マンション・戸建て・店舗・施設など幅広い物件に対応。お客様のライフスタイルや用途に合わせた最適なプランをご提案いたします。
「地域密着」「安心価格」「スピード対応」をモットーに、高品質な床コーティングを提供。
新築住宅の保護、リフォーム、賃貸オーナー様向けの原状回復まで、愛知・名古屋でフロアコーティング・床コーティングをお探しなら、ぜひ当社にお任せください。
愛知県名古屋のリフォームから
原状回復工事・ハウスクリーニングまで
ご相談無料です。
お気軽にお問い合わせください。
![]() 0120-429-172
0120-429-172
受付時間:10:00~18:00
![]() お問い合わせ・ご相談
お問い合わせ・ご相談
お気軽にお問い合わせください。
愛知・名古屋でフロアコーティング・床コーティングの施工をお考えなら、地域密着で多数の実績を誇る当社にお任せください。
フローリングは日常生活の中で傷や汚れがつきやすく、年月が経つと光沢を失ってしまいます。当社のフロアコーティングは、UVコーティングをはじめとする高耐久の施工で、床表面をしっかり保護しながら、美観と清掃性を長期間維持できます。新築住宅の入居前施工では美しい床をそのまま長持ちさせ、子供やペット(犬・猫)がいるご家庭でも安心して暮らせる環境を実現。さらに、賃貸物件の退去後の原状回復やリフォーム工事にも対応しており、資産価値の維持や入居率アップにも効果的です。「地域密着」「安心価格」「スピード対応」をモットーに、愛知・名古屋で幅広い物件に対応可能。戸建て・マンション・アパート・オフィス・施設など、用途に合わせた最適なプランをご提案し、施工後も長く快適に過ごせる空間をお届けします。

当社のフロアコーティングは、木目の自然な美しさを損なうことなく、透明感のある光沢を実現します。
最新のUV硬化樹脂と専用照射機による瞬間硬化技術で、均一でなめらかな塗膜を形成。ホコリや汚れの付着を防ぎながら、傷にも強く、美しい状態を長期間維持します。
愛知・名古屋で新築住宅やリフォーム時に選ばれる理由の一つが、この鏡面のような上質な仕上がりです。

施工後のフロアコーティングは、抗菌・抗ウイルス効果が第三者機関でも確認されており、99%以上の菌やウイルスの増殖を抑制します。
医療・介護施設でも採用が進む高性能コーティングで、日常生活においても清潔な空間を維持可能。
特に小さなお子様やペットと暮らすご家庭におすすめで、衛生的で安心な住まいづくりを実現します。
アルコールや塩素系洗剤、漂白剤などに強く、日常の掃除や薬品清掃にも安心して対応できます。
さらに150℃近い高温にも耐えられるため、万が一タバコの火種や熱い調理器具が床に触れても変色や劣化を起こしにくいのが特長です。
この耐久性により、愛知・名古屋のご家庭はもちろん、商業施設や事務所などでも幅広く採用されている床コーティングです。
ワックス掛けが不要なノンワックス仕様で、日常のお手入れは乾いた布や水拭きだけで十分。皮脂汚れや油汚れも付きにくく、アルコールや中性洗剤でさっと拭き取れば光沢が復元します。
再塗装の必要が少なく、長期的に美しい状態を保つため、メンテナンスコストを大幅に削減できます。新築時はもちろん、愛知・名古屋でのリフォームにもおすすめです。

表面に特殊な微細加工を施すことで、滑りにくさを確保。JIS規格のすべり抵抗値をクリアしており、素足や靴下でも安心して歩けます。
小さな子供や高齢者、ペットがいるご家庭でも快適に過ごせる安全性を実現。リフォームや介護リノベーションにも最適な床コーティングです。

椅子やおもちゃの落下、日常生活で起こる衝撃や摩耗からフローリングを強力にガード。独自の耐摩耗テストをクリアした高耐久コーティングで、一度の施工で長期間美しい状態を維持します。
床の劣化を防ぐことで資産価値を守り、ライフサイクルコストの削減にもつながります。愛知・名古屋のご家庭はもちろん、賃貸物件や施設の原状回復にも効果的です。
愛知・名古屋でフロアコーティングをご検討中なら、SNBコーポレーションにお任せください。
当社は 愛知県で唯一のA1フロアコーティング専門店 として、地域のお客様から厚い信頼をいただいてきました。A1は従来のコーティングと比べて格段に優れた性能を持ち、仕上がりの美しさはもちろん、耐久年数20年以上 を誇るため、一度の施工で長期間フローリングを守ることができます。
さらに、A1フロアコーティングは SIAA認証の抗菌・抗ウイルス機能 を備えており、菌やウイルスの増殖を防ぎ、清潔で安心できる住環境を維持できます。小さなお子様やペットがいるご家庭でも、快適に過ごせる床環境を実現できるのが大きな特長です。
愛知・名古屋で「長持ちするフロアコーティング」「衛生面にも優れた床コーティング」をお探しの方に、当社だけが提供できる確かな強みをご紹介します。

当社は 愛知県で唯一のA1フロアコーティング専門業者 です。A1は従来のフロアコーティングに比べて耐久性・仕上がり・安全性に優れた最高ランクの仕様。専門店としての確かな知識と施工実績で、地域のお客様に最適な床保護サービスをお届けします。

A1フロアコーティングは、一般的なガラスコーティングやシリコンコーティングをはるかに超える 耐久年数20年以上 を誇ります。
一度の施工で長期間フローリングを保護できるため、ワックス不要でメンテナンスコストを大幅に削減。愛知・名古屋で新築やリフォーム時に選ばれる大きな理由の一つです。
A1フロアコーティングは SIAA認証を取得した抗菌・抗ウイルス仕様。99%以上の菌やウイルスの増殖を抑制し、医療機関や介護施設でも採用されている安心の品質です。
小さなお子様やペットがいるご家庭でも清潔な住環境を保てるため、衛生面を重視するお客様から高い評価をいただいています。
フロアコーティングの料金は、施工する床の面積や状態、コーティングの種類によって異なります。新築住宅の入居前施工から、リフォーム・賃貸物件の原状回復まで、お客様のご要望に応じた最適なプランをご提案いたします。SNBコーポレーションでは、愛知・名古屋を中心に数多くの施工実績を持ち、地域のお客様に安心してご依頼いただけるよう わかりやすい料金体系 をご用意しました。
こちらのページでは、UVフロアコーティングをはじめとした各種床コーティングの 参考価格 を一覧でご確認いただけます。「実際にどれくらい費用がかかるのか知りたい」「他社の料金と比較して検討したい」
そんな方のために目安となる価格を整理しています。実際のご依頼時には現地調査を行い、床の状態や面積を確認した上で 正確なお見積もりを無料で作成 いたしますので、安心してご相談ください。
下記はあくまで一例の目安です。
床材や広さ・施工場所・ご予算になど型にはまらない柔軟な対応も可能です!
ご希望やご予算などお気軽にご相談ください!

新築時におすすめの艶ありフロアコーティングプランです。UV硬化樹脂による高光沢仕上げで、木目の美しさを引き立てながら強力に保護。傷や汚れに強く、普段のお手入れも簡単になります。新築住宅の入居前に施工することで、美観と耐久性を長期間維持できます。
150,000円(税別)

自然な質感を好まれる方向けの艶なし仕上げプランです。光沢を抑えたマットな風合いで落ち着いた空間を演出。滑りにくく安全性が高いため、小さなお子様やペットのいるご家庭にも人気です。新築時のフロア保護として幅広く選ばれています。
170,000円(税別)

経年劣化でツヤを失ったフローリングを蘇らせる艶ありプランです。既存の床を丁寧に下地処理し、UVフロアコーティングを施すことで鏡面のような輝きを復活。リフォームや賃貸物件の原状回復にも最適で、資産価値の向上にもつながります。
200,000円(税別)

既存のフローリングに自然なマット仕上げを施すプランです。落ち着いた雰囲気を保ちながら、耐久性・防汚性を向上。艶を抑えたい方や、ナチュラルな木の質感を好まれる方におすすめです。定期的なワックスがけが不要になり、メンテナンス性も抜群です。
220,000円(税別)

新築住宅におすすめの艶ありペットコートプランです。UV硬化樹脂による光沢仕上げで、美しい木目を引き立てながら床をしっかり保護。犬や猫の爪キズやオシッコ汚れに強く、掃除もしやすいため、快適なペットライフを長期間維持できます。
180,000円(税別)

自然な質感を求める方に最適な艶なし仕上げプラン。マットな風合いで落ち着いた空間を演出しつつ、滑りにくい加工でペットの関節や足腰にもやさしい仕様です。新築時のフロア保護と安全性を両立した人気プランです。
200,000円(税別)

経年で傷んだフローリングを美しく蘇らせる艶ありプラン。下地処理を行った上でUVコーティングを施すことで、ペットの爪によるひっかき傷や水濡れにも強い床に改善。高級感のある光沢仕上げで、リフォームや賃貸物件の原状回復にもおすすめです。
230,000円(税別)

既存のフローリングにマットな仕上げを施し、ナチュラルで落ち着いた空間を演出。滑り止め効果によりペットが安心して走り回れる環境を実現します。抗菌・抗ウイルス性能付きで、衛生面も重視したい飼い主様に最適なプランです。
250,000円(税別)








最新の事例はこちらからご覧いただけます!

名古屋市緑区在住 S様
施工当日は、作業の手際も良く、あっという間に美しいコーティングが施されて驚きました。仕上がりは想像以上!フローリングの木目がより一層引き立ち、部屋全体が明るく、そして上品な光沢が出て高級感が増したように感じます。
実際に生活を始めてからは、その効果を日々実感しています。子どもがおもちゃを床で引きずったり、うっかり物を落としたりしても、今のところ全く傷がついていません。食事の際に食べ物や飲み物をこぼしても、サッと拭くだけで跡形もなくキレイになるので、以前のように神経質にならずに済み、本当にストレスが減りました。SIAA抗菌効果のおかげで、子どもたちが床に直接座ったり、寝転んだりして遊んでいても、衛生面での安心感が格段に違います。そして何より、ワックスがけが不要なので、お手入れが本当に楽!共働きで忙しい私たちにとって、これは望外の喜びです。
初期費用はかかりましたが、この安心感と美しさ、そして将来的なメンテナンスの手間を考えれば、A1フロアコーティングを選んで本当に良かったと心から思っています。友人にも自信を持って勧めたいです。

お問い合わせ
フリーダイヤル・メールフォーム・のいずれからでもご相談を承ります。 お客様のご要望や現在のお困りごと、建物の築年数・床材の種類などをヒアリングし、 概算費用や施工可否の目安をその場でご案内。初めての方でも安心してご相談いただけます。

現地確認
専門スタッフがご自宅へ伺い、床材の傷・ワックス層の厚み・含水率を測定。 必要な下地処理や養生範囲を詳細に確認します。 その場で写真を撮影し、最適な施工プランと正式なお見積書を作成・ご提示いたします。

施工日調整・契約書署名
お見積書の内容や使用材料、保証内容を丁寧にご説明。 ご納得いただけましたら、ご都合に合わせて施工日を確定し、 工事請負契約書へご署名・ご捺印。お支払い方法や分割プランもここで決定します。

施工・進捗管理
専門スタッフが安全第一で作業を実施。進捗はLINEやメールでリアルタイム共有し、工期短縮と品質の両立を図ります。

完了検査・お引き渡し
施工後は担当者が最終チェックを実施。お客様立ち合いのもと仕上がりを確認いただき、写真付きの報告書をお渡しして完了となります。

アフターサポート
工事後も気になる点があれば無料で再訪問・修正対応(保証期間内)。長期的な資産価値維持をサポートします。

お問い合わせ
フリーダイヤル・メールフォーム・のいずれからでもご相談を承ります。 お客様のご要望や現在のお困りごと、建物の築年数・床材の種類などをヒアリングし、 概算費用や施工可否の目安をその場でご案内。初めての方でも安心してご相談いただけます

現地調査・お見積り
専門スタッフがご自宅へ伺い、床材の傷・ワックス層の厚み・含水率を測定。 必要な下地処理や養生範囲を詳細に確認します。 その場で写真を撮影し、最適な施工プランと正式なお見積書を作成・ご提示いたします。

正式お見積書のご提出
お見積書の内容や使用材料、保証内容を丁寧にご説明。 ご納得いただけましたら、ご都合に合わせて施工日を確定し、 工事請負契約書へご署名・ご捺印。お支払い方法や分割プランもここで決定します。

施工・進捗管理
専門スタッフが安全第一で作業を実施。進捗はLINEやメールでリアルタイム共有し、工期短縮と品質の両立を図ります。

完了検査・お引き渡し
施工後は担当者が最終チェックを実施。お客様立ち合いのもと仕上がりを確認いただき、写真付きの報告書をお渡しして完了となります。

アフターサポート
工事後も気になる点があれば無料で再訪問・修正対応(保証期間内)。長期的な資産価値維持をサポートします。
一般的なワックスは数ヶ月〜1年程度で効果が落ちるのに対し、フロアコーティングは専用樹脂を硬化させるため、10年以上の耐久性があります。光沢や耐久性、防汚性も段違いで、ワックスがけの手間が不要になります。
はい。新築の場合は下地処理が少なく済むため費用を抑えられ、よりきれいに仕上がります。既存床の場合は下地処理を丁寧に行うため費用はやや高くなりますが、ツヤや質感は新築同様に復元可能です。
有効です。爪キズやオシッコ汚れに強く、滑り止め効果のある艶なしプランもあります。関節に負担をかけにくいため、高齢犬や小型犬・猫にも安心です。抗菌・抗ウイルス対応のプランなら、衛生面でも効果的です。
使用するコーティング材はF☆☆☆☆認定(ホルムアルデヒド放散量最低基準)をクリアしており、安心してご利用いただけます。小さなお子様がハイハイしても安全で、食べこぼしや水分によるシミ防止にも効果があります。
ワックスがけのような定期的なメンテナンスは不要です。ただし、砂や硬いゴミを放置すると傷の原因になるため、日常の掃除機・水拭き程度の簡単なお手入れは必要です。


名古屋市を中心に、愛知県全域のマンション・戸建て住宅やオフィス・店舗まで幅広く対応可能なフロアコーティングサービスです。
UV照射による特殊コーティングで、数秒で瞬時に硬化。臭気や乾燥待ちがほとんど不要なため、営業を止めずに施工できるのも大きな特長です。
高硬度で耐摩耗性に優れ、日常生活の傷や汚れから床材をしっかり保護し、資産価値を長期的に維持。さらに抗菌・防汚機能を備えているため、ペットや小さなお子様がいるご家庭でも安心してお使いいただけます。
ワックスがけが不要となり、メンテナンスコストを削減できる点も多くのオーナー様に選ばれている理由です。
愛知県名古屋のリフォームから
原状回復工事・ハウスクリーニングまで
ご相談無料です。
お気軽にお問い合わせください。
![]() 0120-429-172
0120-429-172
受付時間:10:00~18:00
![]() お問い合わせ・ご相談
お問い合わせ・ご相談
お気軽にお問い合わせください。
対応エリア|愛知・岐阜・三重で幅広く対応
SNBコーポレーションは、愛知県・岐阜県・三重県を中心に、リフォーム・内装工事・フロアコーティング・ハウスクリーニング・原状回復工事など幅広いサービスを提供しています。

名古屋市を中心に、戸建て・
マンション・オフィスまで幅広い施工実績があります。
リフォームや内装工事、退去時の原状回復工事、日常のハウスクリーニングまで柔軟に対応可能です。
千種区・東区・北区・西区・中村区・中区・昭和区・瑞穂区・熱田区・中川区・港区・南区・守山区・緑区・名東区・天白区
豊橋市・岡崎市・一宮市・瀬戸市・半田市・春日井市・豊川市・津島市・刈谷市・豊田市・安城市・西尾市・蒲郡市・犬山市・常滑市・江南市・小牧市・稲沢市・新城市・東海市・大府市・知多市・知立市・尾張旭市・高浜市・岩倉市・豊明市・日進市・田原市・愛西市・清須市・北名古屋市・弥富市・みよし市・あま市・長久手市・東郷町・大治町
岐阜市・大垣市・高山市・多治見市・関市・中津川市・美濃市・瑞浪市・羽島市・恵那市・美濃加茂市・土岐市・各務原市・可児市・山県市・瑞穂市・飛騨市・本巣市・郡上市・下呂市・海津市
津市・四日市市・伊勢市・松阪市・桑名市・鈴鹿市・名張市・尾鷲市・亀山市・鳥羽市・熊野市・いなべ市・志摩市・伊賀市
お気軽にお問い合わせください。![]() 0120-429-172
0120-429-172